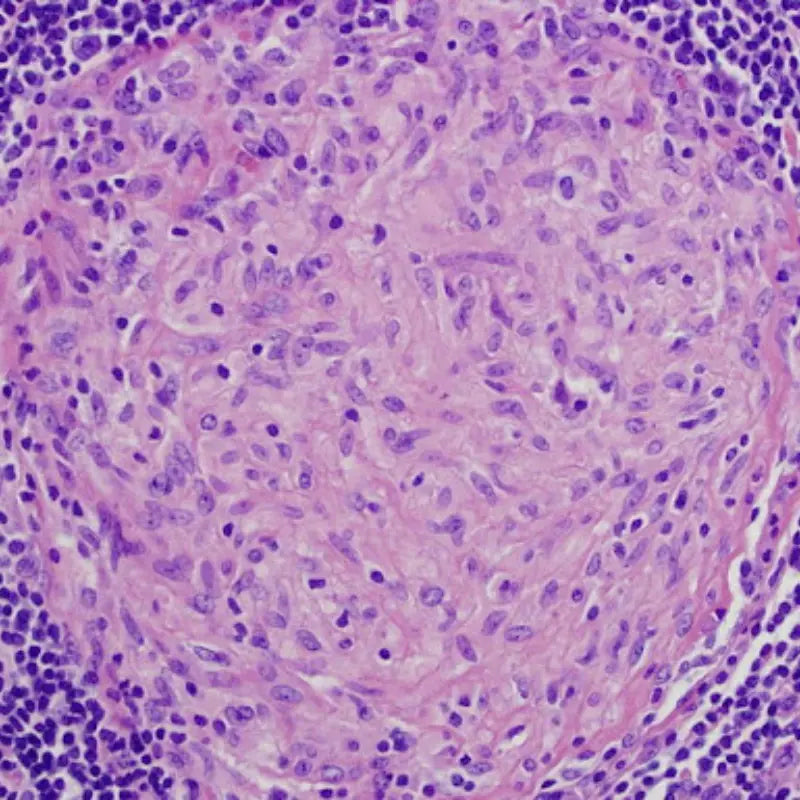
inflammaging 12 hallmarks of aging in dogs 3

The 12 Hallmarks of Aging in Dogs
Dr. JoAnna Pendergrass, DVM 12 min read


Written by Dr. JoAnna Pendergrass, DVM
Veterinarian and freelance medical writer, and founder of JPen Communications. Dr. Pendergrass specializes in clear, evidence-based pet health education to help pet parents make confident, informed decisions.
As our companions for thousands of years, dogs have become closely intertwined with us, studying our behaviors and looking to us for food and protection. And with advances in veterinary medical care and research, dogs are living longer and healthier lives, allowing them to thrive well into their golden years.
But, as with humans, dogs experience numerous changes in their bodies with age, such as graying around the muzzle, decreased mobility, and muscle loss.
In addition to these external old-age changes, myriad aging processes are going on inside a dog’s body at the cellular level. In this article, we’ll review the 12 hallmarks of aging in dogs, which are the internal processes that regulate aging. We’ll also discuss several medical and lifestyle strategies to support aging dogs.

12 Hallmarks of Aging
Because the hallmarks of aging describe cellular and molecular processes, explaining them can involve a heavy dose of scientific technical language. Not to worry, though – we’ll describe them without overwhelming you with scientific jargon.

Image Credit: Darleny Lizardo/Alan Siegel/University at Buffalo North Campus Confocal Imaging Facility.
1. Cellular senescence
Cells go through the cell cycle to replicate. Cellular senescence occurs when the cell cycle stops, and cells stop replicating. However, senescent cells don’t immediately get eliminated. Instead, they accumulate in tissues and release substances that trigger inflammation, increasing the risk of disease in aging dogs.

Image Credit: The Fratta Lab, UCL Institute of Neurology.
2. Loss of proteostasis
Proteostasis is the complex process by which a dog’s body maintains proper functioning of the proteome – the collection of all the proteins in the body. Proteins are critical to cell function, so a loss of proteostasis can lead to cellular senescence and diseases that are associated with protein loss.
Image Credit: Sanjay Mukhopadhyay. Public domain.
3. Inflammaging
Inflammaging combines two terms: inflammation and aging. It describes how chronic, systemic inflammation that occurs in the absence of infection contributes to aging. For example, chronic inflammation damages tissues and increases the risk of age-related diseases in dogs.

Image Credit: Digital CGI rendering of DNA. Artist unknown.
4. Genomic instability
DNA is stored in the nucleus of cells. Over many years, DNA can become damaged by internal or external damage (e.g., ultraviolet rays). In a dog’s younger years, cellular repair mechanisms effectively repair the DNA damage. However, as dogs age, these repair mechanisms become unable to keep pace with the amount of damage, leading to genomic instability. As DNA mutations accumulate and go unrepaired, cellular senescence and cell death can occur.
A major contributor to genomic instability is oxidative damage/stress caused by reactive oxygen species, commonly known as free radicals. This oxidative damage to DNA compromises cellular function.

Image Credit: Dr. Robert Moyzis, UC Irvine, US Human Genome Program.
5. Telomere shortening
Telomeres are the ‘caps’ on the ends of chromosomes, the thread-like strands that contain DNA. Telomeres shorten with each round of cell replication, and a mechanism in cells controls how short telomeres can get before replication stops and cells become senescent. Unfortunately, as telomeres get shorter, DNA becomes more susceptible to damage.

Image Credit: Tomita-Naito, S., et al. iScience (2024).
6. Stem cell exhaustion
Stem cells are precursor cells that develop into specific cells, such as liver or brain cells. They continuously replace cells that become senescent or die in tissues, allowing for tissue renewal. With age, though, the pools of available stem cells become exhausted, and tissues cannot regenerate as quickly, or at all.

Image Credit: Louisa Howard, Dartmouth Electron Microscope Facility. Public Domain.
7. Altered intercellular communication
Cells are constantly communicating with each other via chemical signals. Various mechanisms, such as cellular senescence, can disrupt this communication and contribute to aging.

Image Credit: NIAID, National Institutes of Health (Public Domain). Confocal fluorescence micrograph of HeLa cells.
8. Epigenetic alterations
Epigenetic alterations are changes in gene expression that occur when the chemical structure of DNA is modified, but the DNA sequence remains unchanged. Changes to DNA’s chemical structure can trigger the expression of genes that promote aging. External factors like diet and exercise can influence epigenetics.

Image Credit: Digital CGI rendering of autophagy. Artist unknown.
9. Disabled macroautophagy
Macroautophagy is the process by which cells degrade and eliminate waste. The waste is packaged into tiny vesicles called autophagosomes, then degraded into smaller components. When macroautophagy is disrupted, waste accumulates in the cell, negatively affecting cellular function.

Image Credit: Canva Pro Licensed Asset
10. Mitochondrial dysfunction
Mitochondria are the energy powerhouses of the cell. They produce ATP, the primary energy source for cells. ATP production leads to byproducts such as free radicals, which cause oxidative damage that disrupts mitochondrial function. Mitochondrial dysfunction in aging dogs contributes to the development of brain diseases.

Image Credit: University of Wisconsin–Madison, Department of Botany.
11. Deregulated nutrient sensing
Nutrient sensing refers to the cellular mechanisms that control how a cell responds to nutrients such as glucose and amino acids, and then uses this response to adjust cellular processes, including protein synthesis and macroautophagy. As dogs age, their cells become less effective at nutrient sensing, leading to chronic inflammation, mitochondrial dysfunction, and, eventually, disease.

Image Credit: Canva Pro Licensed Asset
12. Dysbiosis
A dog’s gut contains billions of microorganisms (primarily bacteria) that regulate digestion and promote good overall health. This collection of microorganisms, called the gut microbiome, is tightly controlled. As dogs age, the healthy balance of good bacteria can be disrupted, a condition called dysbiosis. Dysbiosis increases the risk not only of digestive diseases but also of poor immune health, given that 70% of a dog’s immune system is in their gut.
“As dogs age, their bodies go through countless cellular and molecular changes, known as the hallmarks of aging. Medical and lifestyle strategies help promote healthy aging in dogs by minimizing the negative effects of these hallmarks.”

Drugs
Senolytic drugs
Senolytic drugs eliminate senescent cells that accumulate in tissues, thereby minimizing the inflammatory effects caused by the substances they release. Examples of senolytics include dasatinib, a cancer therapy, and quercetin, a natural substance found in plants.
Senomorphic drugs
Unlike senolytic drugs, senomorphic drugs target the substances produced by senescent cells without eliminating the cells themselves. By targeting these substances, senomorphic drugs also help reduce chronic inflammation and subsequent tissue damage associated with aging.
Although clinical research suggests the effectiveness of senolytic and senomorphic drugs in dogs, they are not yet widely used in clinical veterinary medicine.
Medical strategies to promote healthy aging
Aging is inevitable, but old age in dogs doesn’t have to equate to suffering. Various medical and lifestyle strategies help promote healthy aging in dogs and mitigate some of the effects of aging.
Lifestyle strategies to promote healthy aging
Various lifestyle strategies promote healthy aging in dogs.

Diet
A well-balanced diet goes a long way in promoting healthy aging. For example, foods rich in antioxidants, such as blueberries, help combat oxidative damage, thereby reducing DNA damage and genomic instability. Foods that are rich in omega-3 fatty acids, such as fatty fish, help reduce inflammation. Fatty fish is also rich in coenzyme Q10, a substance that supports proper mitochondrial functioning.

Supplementation
Nutritional supplements help minimize the negative effects of aging in dogs. For example, supplements can help counteract mitochondrial dysfunction by supplying cells with precursors of NAD+, which plays a critical role in maintaining mitochondrial function but declines with increasing age.
Hollywood Elixir™, one of La Petite Labs' products, contains NAD+ precursors that help improve mitochondrial function, thereby promoting cellular metabolism and energy production. Antioxidant supplements are also available to counteract oxidative stress and free radical damage.

Exercise
Physical activity has several benefits regarding aging. For example, exercise supports mitochondrial function. It also promotes cellular regeneration, which staves off stem cell exhaustion. Exercise also slows cellular senescence, reduces stress, and even helps prevent altered intercellular communication.

Microbiome modulation
A healthy gut pays dividends in aging dogs, particularly since gut dysbiosis is a hallmark of aging. Products called probiotics (healthy gut bacteria) and prebiotics (dietary fibers that feed the probiotics) both contribute to a healthy and balanced gut microbiome.

Bringing it together
Dogs’ bodies go through countless changes at the cellular level during the aging process. We can’t prevent aging in dogs, but we can be proactive about understanding the hallmarks of aging and supporting dogs as they age, allowing them to enjoy a good quality of life as the gray hairs grow around their muzzles.
References
- Richter, G. Helping Animals Live Longer: Targeting the Hallmarks of Aging. todaysveterinarypractice.com/preventive-medicine/animal-hallmarks-of-aging . Accessed November 20, 2025.
- Lim JR, Yoon JH, Jan HJ. Anti-aging strategies for dogs: current insights and future directions. PMC12520853 (full-text) . J Vet Sci. 2025 Oct; 26(S1): S199–219.
- Jiménez AG. A revisiting of the “hallmarks of aging” in domestic dogs: current status of the literature. PMC10828135 (full-text) . Geroscience. 2024 Feb; 46: 241–255.
- Sândor S, Kubinyi E. Genetic pathways of aging and their relevance in the dog as a natural model of human aging.
- Simon KE, Russell K, Mondino A, Yang C-C, Case BC, Anderson Z, Whitley C, Griffith E, Gruen ME, Olby NJ. A randomized, controlled clinical trial.
Related Reading

